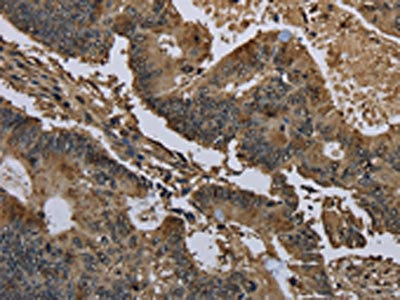
CSB-PA935864

GSTO1
GSTO1,全稱為谷胱甘肽S-轉移酶Omega 1,常見別名包括GSTO、GSTO1-1等。這種蛋白是細胞內的關鍵功能分子,能與谷胱甘肽結合,參與分解體內有毒物質和代謝廢物,同時維持細胞的氧化還原平衡,避免細胞因氧化損傷受損,比如幫助轉化某些易引發細胞傷害的氧化應激分子。
GSTO1與多種疾病存在關聯:阿爾茨海默病患者腦組織中其表達常異常,可能影響神經細胞存活;在炎癥反應及肺癌、結直腸癌等腫瘤中,它的活性變化或與細胞增殖、耐藥性相關。目前針對它的藥物研發處于早期階段,科研人員正嘗試尋找能調節其活性的小分子化合物,希望通過這些物質干預相關疾病進程,但暫無成熟藥物進入臨床應用。
熱銷產品
GSTO1 Recombinant Monoclonal Antibody (CSB-RA040316A0HU)
驗證數據

Flow cytometric analysis of Glutathione S-transferase omega 1 expression in HepG2 cells using Glutathione S-transferase omega 1 antibody. Green, isotype control; red, Glutathione S-transferase omega 1

Immunocytochemical staining of HepG2 cells with Glutathione S-transferase omega 1 antibody. Nuclei were stained blue with DAPI; Glutathione S-transferase omega 1 was stained magenta with Alexa Fluor? 647. Images were taken using leica stellaris 5. Protein abundance based on laser intensity and smart gain: Medium. Scale bar: 20 μm.

Western blotting analysis using Glutathione S-transferase omega 1 antibody. Total cell lysates (30 μg) from various cell lines were loaded and separated by SDS-PAGE. The blot was incubated with Glutathione S-transferase omega 1 antibody and HRP-conjugated goat anti-rabbit secondary antibody respectively.
驗證數據

The image on the left is immunohistochemistry of paraffin-embedded Human liver cancer tissue using CSB-PA935864(GSTO1 Antibody) at dilution 1/60, on the right is treated with fusion protein. (Original magnification: ×200)
The image on the left is immunohistochemistry of paraffin-embedded Human colon cancer tissue using CSB-PA935864(GSTO1 Antibody) at dilution 1/60, on the right is treated with fusion protein. (Original magnification: ×200)

Gel: 8%SDS-PAGE, Lysate: 50 μg, Lane: Human liver cancer tissue, Primary antibody: CSB-PA935864(GSTO1 Antibody) at dilution 1/200, Secondary antibody: Goat anti rabbit IgG at 1/8000 dilution, Exposure time: 20 seconds
Human Glutathione S-transferase omega-1(GSTO1) ELISA kit (CSB-EL009986HU)
驗證數據

貨號:CSB-EL009986HU
規格:96T/48T
靈敏度:7.8 pg/mL
檢測范圍:31.2 pg/mL-2000 pg/mL
These standard curves are provided for demonstration only. A standard curve should be generated for each set of samples assayed.
GSTO1 Antibodies
GSTO1 for Homo sapiens (Human)
| 產品貨號 | 產品名稱 | 種屬反應性 | 應用類型 |
|---|---|---|---|
| CSB-PA009986GA01HU | GSTO1 Antibody | Human,Mouse,Rat | ELISA,WB,IHC,IF |
| CSB-PA935864 | GSTO1 Antibody | Human | ELISA,WB,IHC |
| CSB-PA748508 | GSTO1 Antibody | Human | ELISA,WB,IHC |
| CSB-RA009986A0HU | GSTO1 Recombinant Monoclonal Antibody | Human | ELISA, WB, IHC, IF |
| CSB-RA040316A0HU | GSTO1 Recombinant Monoclonal Antibody | Human, Rat | ELISA, WB, FC, ICC |
GSTO1 Proteins
GSTO1 Proteins for Homo sapiens (Human)
| 產品貨號 | 產品名稱 | 來源 |
|---|---|---|
| CSB-YP009986HU CSB-EP009986HU CSB-BP009986HU CSB-MP009986HU CSB-EP009986HU-B |
Recombinant Human Glutathione S-transferase omega-1 (GSTO1) | Yeast E.coli Baculovirus Mammalian cell In Vivo Biotinylation in E.coli |
GSTO1 ELISA Kit
GSTO1 ELISA Kit for Homo sapiens (Human)
| 產品貨號 | 產品名稱 | 樣本類型 | 靈敏度 |
|---|---|---|---|
| CSB-EL009986HU | Human Glutathione S-transferase omega-1(GSTO1) ELISA kit | serum, plasma, tissue homogenates, cell lysates | 7.8 pg/mL |
















